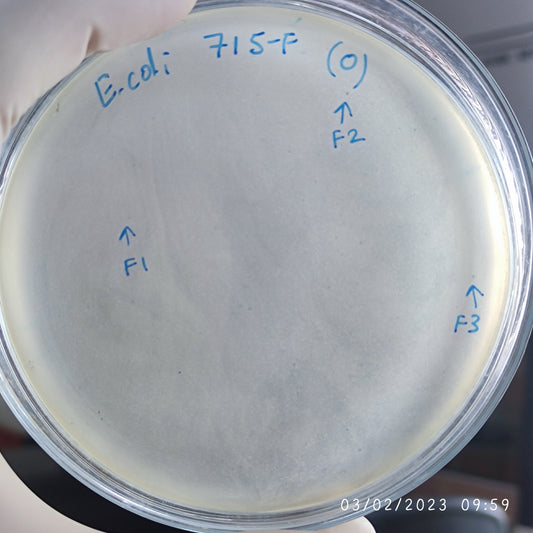
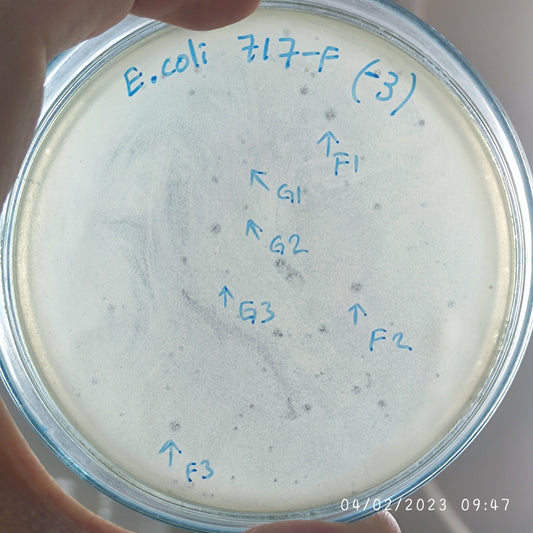
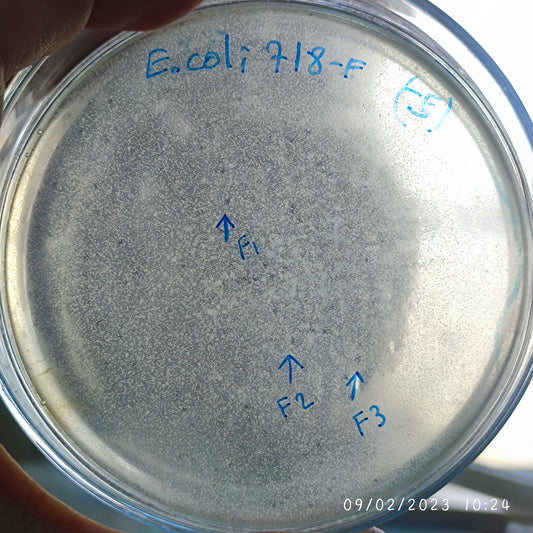
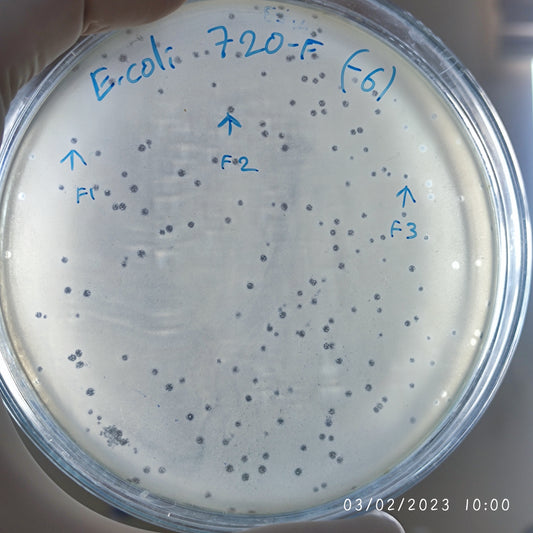
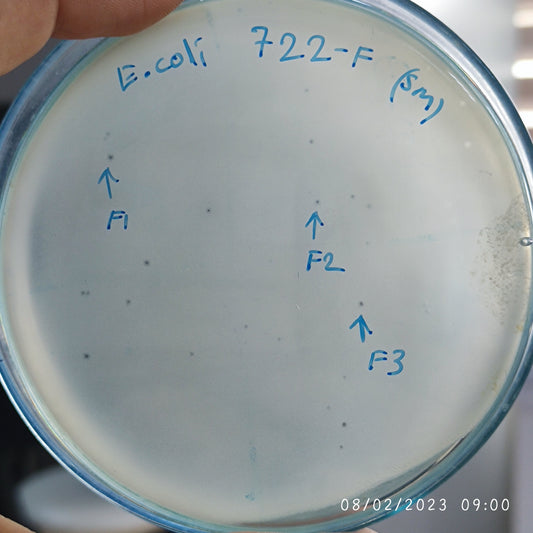
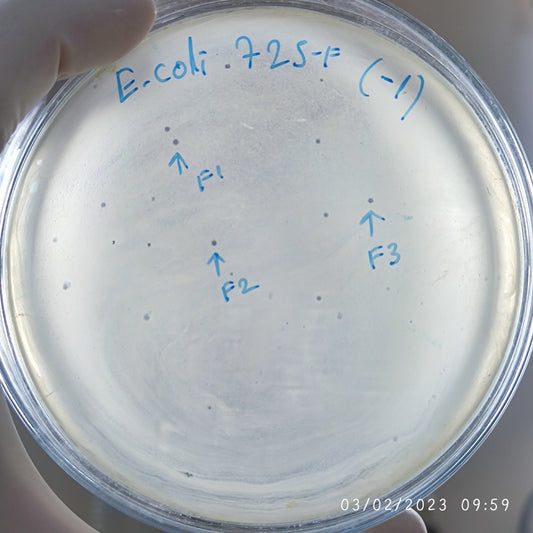
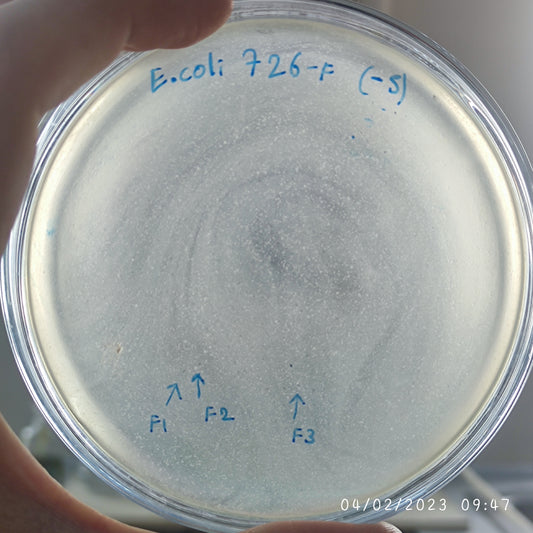
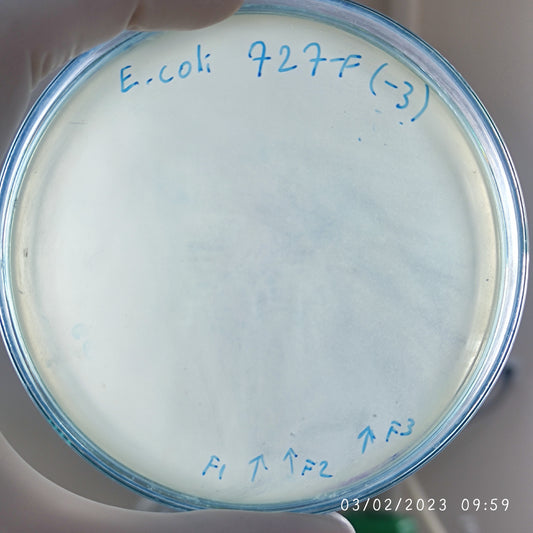
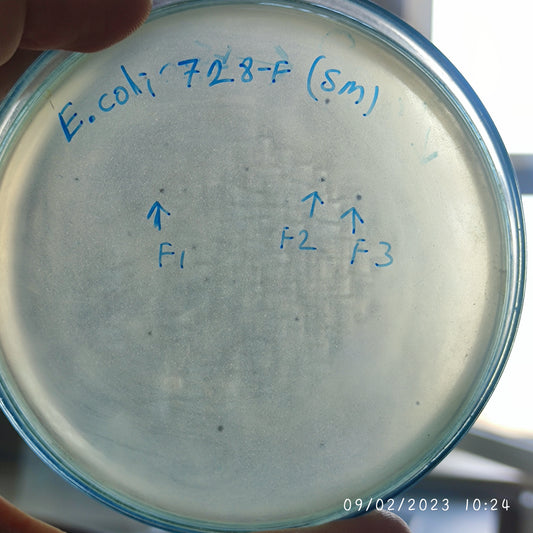

-
Escherichia coli bacteriophage 100715F
Regular price $600.00 USDRegular priceUnit price per -
Escherichia coli bacteriophage 100716F
Regular price $750.00 USDRegular priceUnit price per -
Escherichia coli bacteriophage 100716G
Regular price $750.00 USDRegular priceUnit price per -
Escherichia coli bacteriophage 100717F
Regular price $600.00 USDRegular priceUnit price per -
Escherichia coli bacteriophage 100717G
Regular price $650.00 USDRegular priceUnit price per -
Escherichia coli bacteriophage 100718F
Regular price $700.00 USDRegular priceUnit price per -
Escherichia coli bacteriophage 100719F
Regular price $750.00 USDRegular priceUnit price per -
Escherichia coli bacteriophage 100720F
Regular price $900.00 USDRegular priceUnit price per -
Escherichia coli bacteriophage 100721F
Regular price $700.00 USDRegular priceUnit price per -
Escherichia coli bacteriophage 100722F
Regular price $700.00 USDRegular priceUnit price per -
Escherichia coli bacteriophage 100724F
Regular price $600.00 USDRegular priceUnit price per -
Escherichia coli bacteriophage 100725F
Regular price $750.00 USDRegular priceUnit price per -
Escherichia coli bacteriophage 100726F
Regular price $500.00 USDRegular priceUnit price per -
Escherichia coli bacteriophage 100727F
Regular price $600.00 USDRegular priceUnit price per -
Escherichia coli bacteriophage 100728F
Regular price $750.00 USDRegular priceUnit price per -
Escherichia coli bacteriophage 100729F
Regular price $750.00 USDRegular priceUnit price per